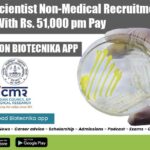
VCRC Job Vacancies 2022

Home Search
microbiology - search results
If you're not happy with the results, please do another search
ICMR-NIRRCH PhD Programme Admissions 2022, Apply Online
ICMR-NIRRCH PhD Admissions 2022, Apply Online
ICMR-NIRRCH PhD Admissions 2022, Apply Online. ICMR-National Institute for Research in Reproductive and Child Health Admission to Ph.D. Programme...
Biotecnika Times Newsletter 30.05.2022 Govt Pharmacopoeia Commission Job, NIP JRF
Biotecnika Times - Govt Pharmacopoeia Commission Job, NIP JRF
Govt Pharmacopoeia Commission for Indian Medicine & Homoeopathy Recruitment
PCIM&H Jobs 2022 – Biotech, Biochem, Life Sciences,...
NERIST Project Associate Job Openings For Life Sciences, Botany
NERIST Project Associate Job Openings For Life Sciences, Botany
NERIST Project Associate Job Openings For Life Sciences, Botany. MSc Microbiology, Botany and Life Sciences project...
Govt Pharmacopoeia Commission for Indian Medicine & Homoeopathy Recruitment
PCIM&H Jobs 2022 - Biotech, Biochem, Life Sciences, Mol Bio Walk-In
PCIM&H Jobs 2022 - Biotech, Biochem, Life Sciences, Mol Bio Walk-In. Microbiology Jobs. Botany...
Biotecnika Times Newsletter 27.05.2022 IISc Intern With Stipend, ICMR-VCRC Scientist, Pfizer
Biotecnika Times - IISc Intern With Stipend, ICMR-VCRC Scientist, Pfizer
DST-Centre for Policy Research-IISc Project Intern With Up to Rs. 12,000 pm Pay
IISc Project Intern...
FSSAI Director Recruitment 2022 – Applications Invited
FSSAI Director Recruitment 2022 - Applications Invited
FSSAI Director Recruitment 2022 - Applications Invited. Deputation jobs at FSSAI 2022. Interested and eligible applicants can check...
ICMR-VCRC Scientist Non-Medical Recruitment With Rs. 51,000 pm Pay
VCRC Job Vacancies 2022 - MSc & PhD Life Sciences, Biotech Apply
VCRC Job Vacancies 2022 - MSc & PhD Life Sciences, Biotech Apply. PhD...
Biotecnika Times Newsletter 26.05.2022 20+ CDFD Jobs, IISER Admission Test 2022
Biotecnika Times - 20+ CDFD Jobs, IISER Admission Test 2022
20+ Research Project Jobs at CDFD – Up to Rs. 78,000 pm Pay, APPLICATION PORTAL...
Biotecnika Times Newsletter 25.05.2022 Govt ZSI Vacancy, CSIR-IGIB PhD program, NITRD Job
Biotecnika Times - Govt ZSI Vacancy, CSIR-IGIB PhD program, NITRD Job
CSIR-IGIB PhD 2022 Program Notification – Applications Invited
CSIR-IGIB PhD 2022 Program Notification – Applications...
IIT Guwahati PhD Biotech & Life Sciences Research Associate Job
IIT Guwahati PhD Biotech & Life Sciences Research Associate Job
IIT Guwahati PhD Biotech & Life Sciences Research Associate Job. PhD Biotechnology and life sciences...
Biotecnika Times Newsletter 24.05.2022 20+ CDFD Jobs, Govt DAE RRCAT Jobs, Govt NDTL
Biotecnika Times - 20+ CDFD Jobs, Govt DAE RRCAT Jobs, Govt NDTL
20+ Research Project Jobs at CDFD – Up to Rs. 78,000 pm Pay,...
ICMR-NIN JRF Leading to PhD in Nutrition and Cancer Areas of Research
NIN Fellowship Jobs 2022 - Biotech, Biochem, Mol Bio & Microbiology Apply
NIN Fellowship Jobs 2022 - Biotech, Biochem, Mol Bio & Microbiology Apply. Project...
IBSD Job Openings For MSc Life Sciences, Biotech – Applications Invited
IBSD Job Openings For MSc Life Sciences, Biotech - Applications Invited
IBSD Job Openings For MSc Life Sciences, Biotech - Applications Invited. Institute of Bioresources...
20+ Research Project Jobs at CDFD – Up to Rs. 78,000 pm Pay, Apply...
CDFD Research Project Jobs 2022 - Online Application Process
CDFD Research Project Jobs 2022 - Online Application Process. MSc/ BTech and PhD jobs at the...
Biotecnika Times Newsletter 23.05.2022 CUET PG 2022, Govt ILS Job, DIAGEO Job, NIIH PhD
Biotecnika Times - CUET PG 2022, Govt ILS Job, DIAGEO Job, NIIH PhD
CUET PG 2022 Online Registrations Open – Check Exam Pattern, Question Paper,...